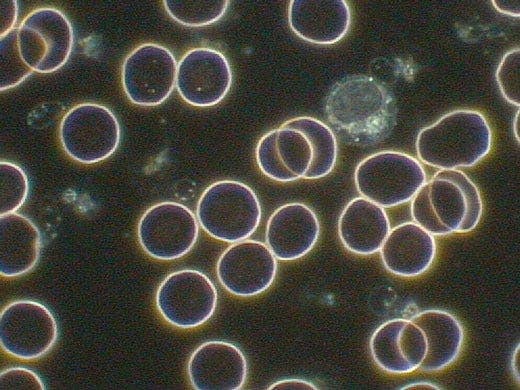

CX43/CX33 정립 현미경
CX43 및 CX33 생물 현미경은 장시간의 일상적인 관찰 중 편안함을 유지하게 해줍니다. 현미경 프레임은 손으로 쉽게 제어 가능하며, 인체공학적으로 극대화된 제어 손잡이의 위치는 작업 효율을 향상시킵니다. 최소한의 움직임으로 한 손으로 신속하게 표본을 설치하고 다른 손으로 초점을 조정하고 스테이지를 조작할 수 있습니다. 또한 현미경은 디지털 이미징을 위한 카메라 포트를 장착할 수 있습니다.

CX43/CX33
간편한 고처리량 일상 현미경
CX43 및 CX33 생물 현미경은 장시간의 일상적인 관찰 중 편안함을 유지하게 해줍니다. 현미경 프레임은 손으로 쉽게 제어 가능하며, 인체공학적으로 극대화된 제어 손잡이의 위치는 작업 효율을 향상시킵니다. 최소한의 움직임으로 한 손으로 신속하게 표본을 설치하고 다른 손으로 초점을 조정하고 스테이지를 조작할 수 있습니다. 또한 현미경은 디지털 이미징을 위한 카메라 포트를 장착할 수 있습니다.
최소한의 조정으로 선호 관찰 조건 유지
- CX43
- CX33
일관된 색온도를 지닌 균일한 조명
CX43/CX33 LED 조명은 즉각적이고 장기적으로 여러 가지 이점을 제공합니다.
- 표본을 자연스러운 색상으로 볼 수 있도록 일광 조건 생성
- 밝기를 조정하는 데 시간을 낭비하지 않도록 어떤 밝기에서도 일정한 색온도
- 밝기 수준이 전체적으로 안정적으로 유지되는 60,000시간의 긴 수명
편안한 보기를 위한 고정식 Köhler 조명
CX43 및 CX33 현미경은 고정식 Köhler 조명을 제공하므로 콘덴서를 조정하지 않고도 적절한 조명을 얻을 수 있습니다.




장시간 사용 중에도 편안함 유지
- CX43
- CX33
인체공학적으로 배치된 초점 손잡이
낮은 위치의 초점 손잡이를 사용하여 책상 위에 손과 팔뚝을 놓고 편안한 자세를 유지하면서 관찰을 수행할 수 있습니다. 초점 스토퍼는 고배율에서 작업할 때 표본이 실수로 대물렌즈와 부딪히는 것을 방지합니다.
인체 공학적 스테이지 및 접안 렌즈의 위치
CX43 및 CX33 현미경은 실험실에서 장시간 사용할 수 있도록 지원하는 기능들을 제공합니다.
- 편안함을 높이고 피로를 줄여주는 낮은 위치의 스테이지
- 표본을 원활하게 설정하고 확인할 수 있도록 시선 위치의 스테이지 가시성
- 가벼운 터치만으로 제어 가능하며, 표본을 신속하고 편안하게 볼 수 있게 해주는 낮은 위치의 스테이지 손잡이
응용 기술
평면 이미지에 대한 뛰어난 광학 성능
- CX43
- CX33
CX43 및 CX33 현미경은 넓은 시야에 걸쳐 높은 이미지 평탄도와 선명한 이미지를 제공하는 Plan 아포크로맷 대물렌즈와 함께 사용할 수 있습니다. 일상적인 관찰 중에 균일한 조도로 표본을 명확하게 볼 수 있습니다.
*CX43은 모든 UIS2 대물렌즈와 호환되며, CX33은 특별히 설계된 Plan 아포크로맷 대물렌즈와 함께 제공됩니다.

다양한 응용 분야에 대한 유연성
- CX43
CX43 현미경은 다음과 같은 다양한 관찰 방법을 제공하는 표준 범용 콘덴서를 사용합니다.
- 명시야
- 암시야
- 위상차
- 형광
- 간이 편광
콘덴서에서 상단 렌즈를 이동하지 않고도 배율을 2배에서 100배까지 변경할 수 있습니다.
간단한 형광 관찰
- CX43
형광 관찰은 간단하고 쉽습니다. 소형 형광 조명 장치를 현미경 프레임에 연결하고 콘덴서 터렛을 FL 위치로 설정합니다. LED 광원은 중앙에 고정되어 있으며, 수명이 60,000 시간입니다. 콘덴서 터렛을 FL 위치로 설정하여 투과된 조명을 차단함으로써 콘덴서 상단에서 들어오는 입사광에 의한 배경 노이즈를 감소시킵니다.




부드러운 배율 변경
- CX43
- CX33
회전식 노즈피스는 낮은 높이에 위치하여 팔꿈치를 책상에 편안하게 놓은 상태에서 대물렌즈를 쉽게 변경할 수 있습니다.
또한 노즈피스는 내부를 향하므로 표본을 교체하거나 이멀젼 오일을 추가할 때 더 넓은 작업 공간을 제공합니다.
최대 5개의 대물렌즈 지원
- CX43
유연성을 높이기 위해 회전식 노즈피스에 최대 5개의 UIS2 대물렌즈를 지원합니다. 일반적인 대물렌즈 외에도 넓은 면적 관찰을 위한 2배율 대물렌즈 또는 위상차용 대물렌즈를 선택할 수 있습니다.



간단한 조리개 정지 동작으로 대비 향상
- CX43
- CX33
조리개 막을 좁혀 대비를 빠르게 향상시킵니다. 이 기술은 콘덴서를 조정할 때 더 낫지는 않더라도 동일한 이미지를 제공합니다.
원하는 대비 수준 및 관찰 설정 유지
- CX43
CX43 현미경은 관찰 워크플로를 개선하고 작동 오류를 줄이는 데 도움이 되는 두 가지 고정 핀을 제공합니다.
- 조리개 막에 고정 핀을 사용하여 원하는 대비 수준을 유지합니다.
- 원하는 경우 콘덴서의 고정 핀을 사용하여 현미경을 명시야 관찰로 유지할 수 있습니다.




관찰 스타일에 적합한 표본 고정 장치
- CX43
- CX33
효율성 향상을 위해 다양한 스테이지 부속품을 사용할 수 있습니다. 표본 고정 장치 시트를 사용할 때 고정 장치로 표본을 집을 필요가 없습니다. 대신 고정 장치를 사용하면 슬라이드가 시트에 있는 동안 쉽게 이동시킬 수 있습니다. 이중 표본 고정 장치는 큰 표본 또는 2개의 표준 크기 유리 슬라이드 2개를 보관할 수 있습니다.
디지털카메라와 헤드업 디스플레이로 이미지를 쉽게 캡처하고 보기
무선 LAN 지원 EP50 디지털카메라를 사용하여 동료와 이미지를 쉽게 공유하고 표시하세요.이 카메라를 당사 CX 시리즈 현미경과 결합하여 일반 실험실을 디지털 실험실로 바꾸어보세요.헤드업 디스플레이를 통해 그룹 활동 중 결과를 쉽게 볼 수 있습니다.번갈아 가며 접안렌즈를 볼 필요 없이 누구나 실시간으로 표본 관찰 결과를 볼 수 있습니다.
* 일부 국가에서는 타사 제품을 사용하지 못할 수 있습니다.

Observation Methods
CX43 범용 콘덴서는 다양한 관찰 방법과 향후 업그레이드 기능을 제공합니다. 다섯 가지 위치의 회전식 노즈피스와 함께, 하나의 현미경 프레임으로 여러 응용 분야에서 사용할 수 있습니다.
명시야
CX43 CX33

신장
명시야
CX43 CX33

자궁경부 세포
명시야
CX43 CX33

결핵균
암시야
CX43 CX33
적혈구와 백혈구
위상차*
CX43

HeLa 세포
간단한 편광
CX43

아밀로이드
형광
CX43

결핵균
형광
CX43

신장 사구체
* 비록 헬라 세포가 의료 연구에서 가장 중요한 세포주가 되었다고 해도, 과학에 대한 Henrietta Lacks의 공헌이 동의를 받지 않은 것이었다는 것을 인정해야만 합니다. 이로 인해 면역학, 전염병, 암에 대한 중요한 발견이 이루어졌지만 사생활, 윤리, 의학적 동의에 대한 중요한 논의도 촉발되었습니다.
Henrietta Lacks의 삶과 현대 의학에 대한 그녀의 공헌을 알아보려면 여기를 클릭하세요.
http://henriettalacksfoundation.org/
사양
CX43
| 관찰 방법 | 명시야 | ✓ | |
| 암시야 | ✓ | ||
| 위상차 | ✓ | ||
| 형광 (Blue/Green Excitations) | ✓(Blue Excitation only) | ||
| 간이 편광 | ✓ | ||
| 광원 | 투과 쾰러 광원 | LED 램프 | ✓ |
| 형광 조명 | LED 램프 | ✓ | |
| 포커스 | 포커스 메커니즘 | 스테이지 포커스 | ✓ |
| 조동 나사 스트로크 | 15 mm | ||
| 특징 | Coarse adjustment limit stopper Torque adjustment for coarse adjustment knob |
||
| 리볼빙 노즈피스 | 수동 터렛 | 표준 (5 포지션) | ✓ |
| 스테이지 | 수동 | 오른손 제어 수동 스테이지 |
Built-in X: 76 mm, Y: 52 mm |
| 콘덴서 | 수동 | 아베(Abbe) 콘덴서 | NA 1.25 (2X–100X) |
| Observation Tubes | Standard (FN18) | Tilting Binocular | ✓ |
| 표준 (FN20) | 이안 경통 | ✓ | |
| 삼안 경통 | ✓ | ||
| 경통 경사각 |
Binocular, Trinocular 30° Tilting Binocular 30°–60° |
||
| 삼안 경통 광로 선택 (카메라:눈) | 50 % : 50 % | ||
| 동공사이거리 조절 | 48–75 mm | ||
| 치수 (W x D x H) | 211 mm × 376 mm × 393 mm (8.3 in. × 14.8 in. × 15.5 in.) (standard configuration) | ||
| 무게 | Approx. 7.3 kg (16.1 lb) | ||
CX43 현미경 시스템에는 스테이지와 콘덴서가 기본 포함되어 있습니다.
CX33
| 관찰 방법 | 명시야 | ✓ | |
| 암시야 | ✓ | ||
| 광원 | 투과 쾰러 광원 | LED 램프 | ✓ |
| 포커스 | 포커스 메커니즘 | 스테이지 포커스 | ✓ |
| 조동 나사 스트로크 | 15 mm | ||
| 특징 | Coarse adjustment limit stopper Torque adjustment for coarse adjustment knob |
||
| Revolving Nosepiece | Manual | Standard (4 positions) | ✓ |
| 스테이지 | 수동 | 오른손 제어 수동 스테이지 |
Built-in X: 76 mm, Y: 52 mm |
| 콘덴서 | 수동 | 아베(Abbe) 콘덴서 | NA 1.25 (4X–100X) |
| 경통 | 표준 (FN20) | 삼안 경통 | ✓ |
| 경통 경사각 | 30° | ||
| 삼안 경통 광로 선택 (카메라:눈) | 0%:100%, 100%:0% | ||
| 동공사이거리 조절 | 48–75 mm | ||
| 치수 (W x D x H) | 211 mm × 397 mm × 430 mm (8.3 in. × 15.6 in. × 17 in.) | ||
| 무게 | Approx. 7.0 kg (15.4 lb) | ||
| 대물렌즈 | Plan Achromat 4X NA 0.1 W.D. 27.8 mm 10X NA 0.25 W.D. 8.0 mm 20X NA 0.4 W.D. 2.5 mm (optional) 40X NA 0.65 W.D. 0.6 mm 100XOil NA 1.25 W.D. 0.13 mm (optional) |
||
CX33 현미경 시스템에는 대물렌즈, 접안 렌즈, 삼안 헤드, 스테이지 및 콘덴서가 기본 포함되어 있습니다.
리소스
애플리케이션 노트
비디오
CX43/CX33: Olympus CX43/CX33 현미경의 향상된 인체공학적 특징